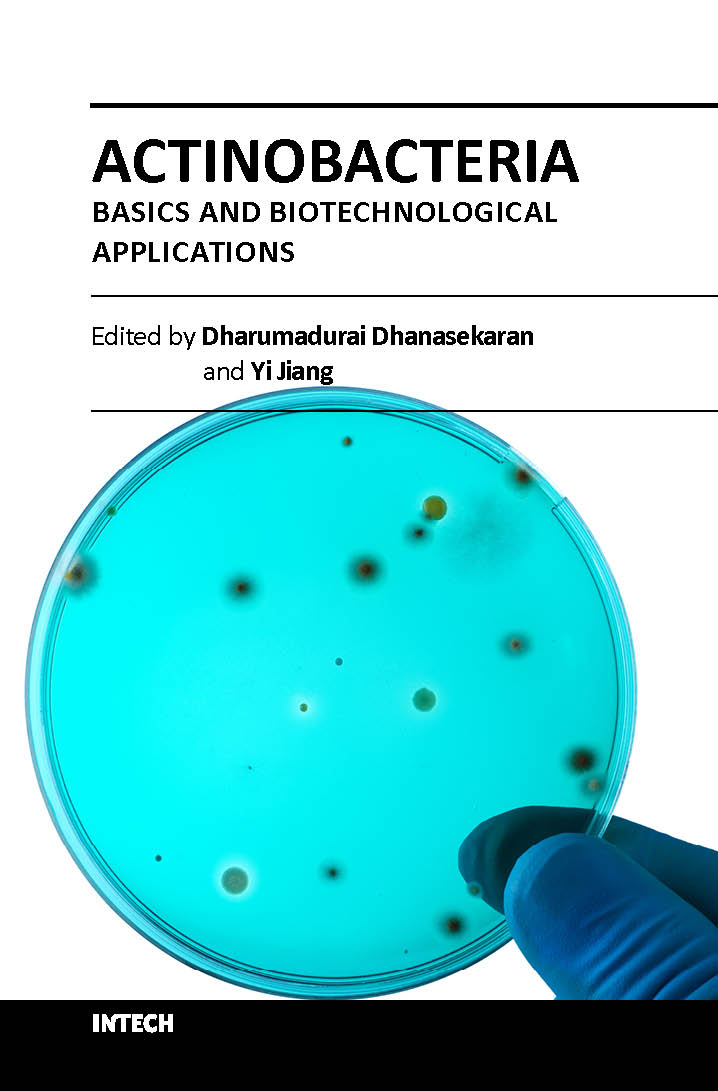
Actinobacteria basics and biotechnological applications (hb 2018)

This book presents an introductory overview of Actinobacteria with three main divisions: taxonomic principles, bioprospecting, and agriculture and industrial utility, which covers isolation, cultivation methods, and identification of Actinobacteria and production and biotechnological potential of antibacterial compounds and enzymes from Actinobacteria. Moreover, this book also provides a comprehensive account on plant growth-promoting (PGP) and pollutant degrading ability of Actinobacteria and the exploitation of Actinobacteria as ecofriendly nanofactories for biosynthesis of nanoparticles, such as gold and silver. This book will be beneficial for the graduate students, teachers, researchers, biotechnologists, and other professionals, who are interested to fortify and expand their knowledge about Actinobacteria in the field of Microbiology, Biotechnology, Biomedical Science, Plant Science, Agriculture, Plant pathology, Environmental Science, etc.
| Specifications |
Descriptions |
| ISBN |
9789535122487 |
| Published Year |
2018 |
| Binding |
Hardcover |
| Subject |
Biotechnology |
| Pages |
400 |
| Weight |
0.4 (In Kg) |
| Readership |
NA |